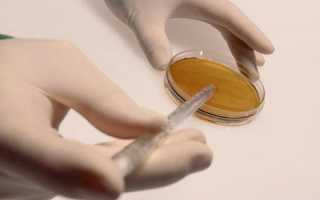
О чем говорит агглютинация в спермограмме

Если паре не удается завести ребенка в течение длительного времени, необходимо решиться и пройти углубленное обследование, чтобы определить причину бесплодия. Возможно, причиной является агглютинация сперматозоидов. Нужно сделать анализ спермы и узнать, есть ли агглютинация в спермограмме. Результаты такого обследования могут дать оценку состояния мужского здоровья. После этого врач примет решение о возможности лечения или искусственного оплодотворения.
Агглютинация в спермограмме: что это?
О чем она может рассказать профильному врачу?
Термином «агглютинация сперматозоидов» (семенных клеток) обозначается патология мужской репродуктивной системы, при которой клетки слипаются. В нормальном состоянии эти семенные клетки передвигаются и отталкиваются под воздействием отрицательно заряженных частиц. Этим обеспечивается их подвижное поведение, необходимое для достижения яйцеклетки и оплодотворения.
Выделяются:
- Истинная агглютинация, при которой сперматозоиды склеиваются друг с другом.
- Ложная (неспецифическая) агглютинация. В этом случае сперматозоиды слипаются с частичками разрушенных клеток, комочками слизи, клетками эпителия, антителами собственного организма.
Агглютинация в спермограмме является важным показателем, на который обращают внимание врачи при оценке мужского репродуктивного здоровья. По мнению специалистов, наличие агглютинации может свидетельствовать о различных патологиях, таких как инфекции, воспалительные процессы или аутоиммунные реакции. Врачи подчеркивают, что агглютинация приводит к снижению подвижности сперматозоидов, что может затруднять зачатие. Кроме того, этот показатель может указывать на необходимость более глубокого обследования для выявления причин нарушения. Важно, чтобы мужчины, столкнувшиеся с подобной проблемой, не откладывали визит к врачу, так как своевременная диагностика и лечение могут значительно повысить шансы на успешное зачатие.

Каковы причины, вызывающие развитие этой патологии?
Развитие инфекции.
- Иммунологический фактор. В здоровом организме мужчины специфический (гематотестикулярный) барьер эпителия защищает семенные канальца. Он препятствует взаимодействию сперматозоидов с системой иммунитета через кровеносные сосуды. Так как иммунитет играет роль охранника в организме, он иногда ошибочно начинает защищать организм от собственных семенных клеток, повреждая их. В результате хромосомной аномалии иммунитет начинает воспринимать сперматозоиды в качестве чужеродных элементов. Поэтому организм вырабатывает антиспермальные антитела, которые обездвиживают сперматозоидов, и они начинают активно склеиваться.
Гематотестикулярный барьер может быть поврежден при некоторых мужских болезнях:
- повреждение яичек в результате травмы;
- осложнения хирургических оперативных вмешательств;
- болезни мужских репродуктивных органов.
Какие последствия имеет эта патология для пары, желающей иметь детей?
Склеенные клетки теряют возможность продвижения вперед, к яйцеклетке. Поэтому оплодотворение яйцеклетки не происходит. В случае обнаружения врачами агглютинации сперматозоидов считается необходимым проведение бактериологического посева спермы. Это нужно для оценки потенциальной угрозы наличия инфекции. Нужно определить, может ли она привести к агглютинации сперматозоидов и бесплодию мужчины. Склеивание сперматозоидов не дает возможности произойти оплодотворению.
В чем заключается диагностика состояния эякулята при этой патологии?
Анализ спермы обнаруживает различные степени этого отклонения от нормы. Обнаружить ее можно с помощью спермограммы. Направление на этот анализ дает андролог.
Как определяется агглютинация сперматозоидов?
Это исследование мужской спермы проводится с использованием микроскопа. Оно считается единственным и основным анализом, позволяющим прогнозировать мужскую способность к оплодотворению. Но однозначно отрицательного результата спермограмма не дает. Даже серьезные отличия от нормальных характеристик означают лишь более низкую способность зачать ребенка обычным способом.
Агглютинация в спермограмме — это процесс, при котором сперматозоиды слипаются друг с другом, что может указывать на различные проблемы с мужским здоровьем. Многие мужчины, столкнувшиеся с этой проблемой, выражают свои опасения по поводу фертильности и возможности зачатия. Важно отметить, что агглютинация может быть вызвана инфекциями, антителами или другими факторами. Некоторые специалисты подчеркивают, что это состояние может быть обратимым, если выявить и устранить основную причину. Мужчины часто обсуждают необходимость регулярных обследований и анализов, чтобы контролировать свое репродуктивное здоровье. Важно помнить, что своевременная диагностика и лечение могут значительно повысить шансы на успешное зачатие.
Что нужно делать, чтобы правильно подготовиться к проведению спермограммы?
- Воздержание от половой жизни в течение 2-7 дней.
- Отказ от приема спиртных напитков, лекарств, кофе на такой же срок.
- В этот же период нельзя принимать водные процедуры, загорать и допускать воздействие на организм высоких температур.
Как собирается материал для спермограммы?
- эякулят собирается в презервативе, используя мастурбацию. Лабораторное помещение оборудовано специально отведенной комнатой с надежно закрытой изнутри дверью и эротическими журналами;
- собранный материал должен быть передан лаборантам не позднее, чем в трехчасовой срок с момента эякуляции;
- для более точного результата этот материал сдается для исследования неоднократно.

- Спермограмма обязательно должна содержать указание на степень склеивания сперматозоидов (агглютинации). Она выражается количеством плюсов.
- Пациенту не следует впадать в отчаяние, если получен плохой результат в ходе этого исследования. Спермограмма должна быть сделана повторно. Следующие характеристики его спермы могут быть другими.
- Если в результате данного анализа установлено наличие патологического склеивания сперматозоидов, можно считать, что имеет место:
- сбой иммунной системы;
- проявление аутоиммунного воспалительного процесса;
- хронический воспалительный процесс в мужских половых железах.
Может ли стать отцом мужчина с таким результатом анализа?
Агглютинация в спермограмме не исключает возможности зачать ребенка естественным путем. Но сниженная подвижность сперматозоидов при этом наблюдается почти во всех случаях.
Что следует делать при выявлении агглютинации сперматозоидов
В чем заключается лечение? Как лечить агглютинацию сперматозоидов?
Расшифровка результатов спермограммы проводится квалифицированным врачом. В случае выяснения в процессе диагностики, что агглютинация обусловлена воспалением в мужских репродуктивных органах, сначала проводится терапия воспалительного процесса (эпидидимита, простатита, орхита, везикулита). Эти болезни нужно лечить. Нередко при благоприятном исходе лечения агглютинация исчезает.
- Часто воспалительный процесс исключен, но налицо значительные отклонения результатов от нормы. Кроме того, мужчина не имеет возможности зачатия естественным путем. Тогда используются современные репродуктивные технологии оплодотворения.
В чем заключается суть этих методов преодоления бесплодия:
- антитела, склеивающие семенные клетки, отделяются от сперматозоидов;
- семенная жидкость отмывается, чтобы снова сделать клетки подвижными;
- при условии, что имеется достаточное число активных сперматозоидов, проводится введение спермы в матку с использованием катетера;
- в результате этой краткосрочной процедуры значительно увеличивается вероятность оплодотворения;
- такую репродуктивную технологию называют искусственной инсеминацией.
Иногда оплодотворение методом искусственной инсеминации реализовать невозможно, так как у мужчины нет достаточного количества семенных клеток. Тогда такой процесс осуществляется в пробирке. Извлекаются женские яйцеклетки и соединяются с отмытыми мужскими сперматозоидами. Но это не всегда имеет желательный результат.

В этой ситуации имеется возможность оплодотворения с использованием интрацитоплазматической инъекции сперматозоидов. Это успешная, но значительно более дорогая и сложная репродуктивная технология. Но она имеет большое значение для людей, желающих иметь ребенка.
Практически каждый мужчина мечтает о ребенке. Это большое счастье для семьи, но не всегда паре удается зачать детей обычным способом.
Современная медицина обладает большими возможностями для оказания помощи людям в таких ситуациях.
Если сделать спермограмму, можно выявить причины бесплодия мужчины. Одновременно со спермограммой проводятся и другие исследования. Агглютинацию сперматозоидов можно вылечить. Врач находит возможности лечения и зачатия ребенка.

Никогда не нужно отчаиваться. Всегда есть пути для достижения наилучшего результата. Нужно просто терпеливо и настойчиво лечиться. Современные репродуктивные технологии уже помогли многим парам. Есть много возможностей для лечения. И тогда в семье появится маленькое чудо: симпатичная девчушка с косичками или озорной мальчик. Жизнь наполнится новым смыслом.
Вопрос-ответ
Можно ли забеременеть, если у мужчины агглютинация?
Агглютинация 1 степени. Подвижность большинства клеток остается нормальной, и шансы на естественное зачатие высоки. Может быть обнаружена случайно при обследовании и часто не требует серьезного лечения, хотя иногда указывает на начало воспалительного процесса или наличие антиспермальных антител.
Что значит агглютинация ++?
Резко выраженная («+++») – более 20 крупных скоплений, количество сперматозоидов в которых превышает 20 штук. Тяжелая («++++») – все сперматозоиды склеены друг с другом.
Что такое агрегационная агглютинация сперматозоидов?
Агрегация – это прилипание как подвижных, так и неподвижных сперматозоидов к тяжам слизи или несперматозоидам. Агглютинация же – это тенденция подвижных сперматозоидов к образованию комков, и её можно классифицировать по степени агглютинации и вовлечённым структурам сперматозоидов.
К чему приводит агглютинация крови?
В отличие от агрегации, агглютинация может привести к гемолизу – разрушению эритроцитов, что представляет серьезную опасность для организма. При этом процессе в кровь выделяется свободный гемоглобин, который может повредить различные органы, особенно почки.
Советы
СОВЕТ №1
Обратите внимание на уровень агглютинации в спермограмме. Нормальные показатели могут варьироваться, и их отклонение может указывать на проблемы с фертильностью. Если вы заметили высокую агглютинацию, стоит обратиться к врачу для дальнейшего обследования.
СОВЕТ №2
Не игнорируйте другие показатели спермограммы. Агглютинация может быть связана с другими факторами, такими как количество и подвижность сперматозоидов. Полный анализ поможет получить более полное представление о состоянии репродуктивной системы.
СОВЕТ №3
Обсудите результаты спермограммы с квалифицированным специалистом. Только врач сможет правильно интерпретировать данные и предложить необходимые шаги для улучшения ситуации, если это потребуется.
СОВЕТ №4
Следите за своим образом жизни. Здоровое питание, регулярные физические нагрузки и отказ от вредных привычек могут положительно сказаться на качестве спермы и снизить уровень агглютинации.

 Развитие инфекции.
Развитие инфекции.
 Расшифровка результатов спермограммы проводится квалифицированным врачом. В случае выяснения в процессе диагностики, что агглютинация обусловлена воспалением в мужских репродуктивных органах, сначала проводится терапия воспалительного процесса (эпидидимита, простатита, орхита, везикулита). Эти болезни нужно лечить. Нередко при благоприятном исходе лечения агглютинация исчезает.
Расшифровка результатов спермограммы проводится квалифицированным врачом. В случае выяснения в процессе диагностики, что агглютинация обусловлена воспалением в мужских репродуктивных органах, сначала проводится терапия воспалительного процесса (эпидидимита, простатита, орхита, везикулита). Эти болезни нужно лечить. Нередко при благоприятном исходе лечения агглютинация исчезает.